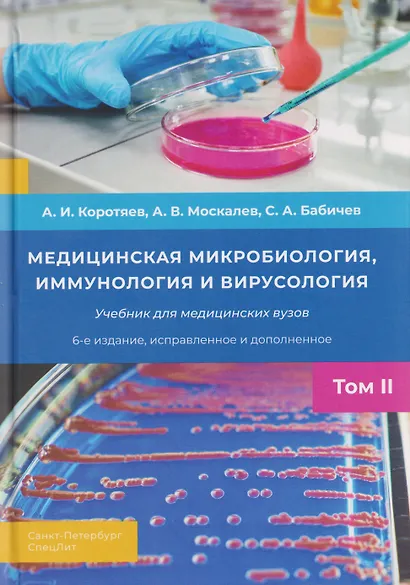
Медицинская микробиология, иммунология и вирусология. Том II - фото 1

Москалев Александр Витальевич, Коротяев Александр Иванович, Бабичев Сергей Анатольевич: Медицинская микробиология, иммунология и вирусология. Том II
Купили 20 раз
Купить в партнерских магазинах
О товаре
Учебник включает в себя курс общей микробиологии, иммунологии, вирусологии,бактериологии, микологии и санитарной микробиологии.В разделах вирусологии, бактериологии, микологии представлены сведения об основных биологических свойствах биологических агентов и о заболеваниях, которые они вызывают.Дополнительно к предыдущим изданиям введены новые части: «Санитарная микробиология» и «Патогенные грибы». Гораздо шире и на современном уровне представлены сведения о клеточных и гуморальных факторах врожденного и адаптивного иммунитета.В приложениях представлены основные требования противоэпидемического режима при работе в бактериологической лаборатории, виды микроскопирования и основные биологические методы исследования.
Учебник предназначен для студентов, аспирантов и преподавателей высших медицинских учебных заведений, микробиологов всех специальностей и практических врачей.
Характеристики
- Раздел:
- Микробиология
- Издательство:
- СпецЛит
- ISBN:
- Год издания:
- 2025
- Количество страниц:
- 677
- Формат:
- 37x168 мм
- Вес:
- 1.07 кг
Похожие товары
Отзывов ещё нет — вы можете быть первым.